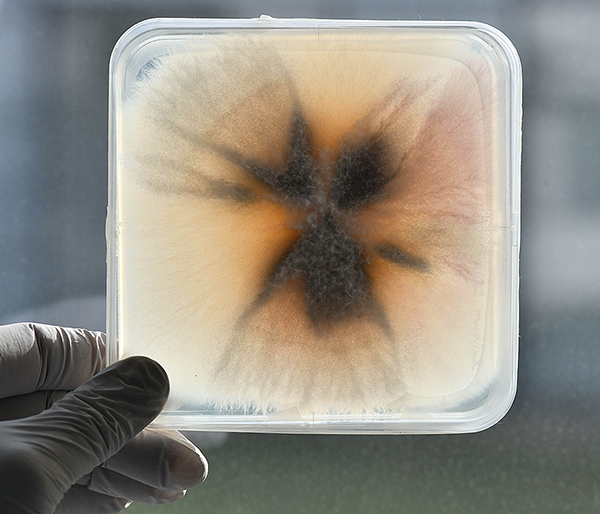

Biotechnologies
Our microbiologists take advantage of the great diversity of microorganisms and enzymes to develop
innovative ways to produce biomolecules. Using liquid and solid-state fermentation processes, they convert agro-resources
and biorefineries by-products into platform chemicals.
Our biotechnology laboratory is equipped with a set of 1L fermentors, a set of 5L fermenters, and one 20L fermentor
for liquid state fermentation. It also includes solid-state fermentation equipment such as non-stirred thermostatically
controlled chambers and a halogene moisture analyser. To complement its fermentation activity, URD ABI has also a
molecular biology laboratory with quantitative PCR, electrophoresis, electroporation, gel dock and an Akta Start
purification system. Finally, our biotechnology platform possesses a set of equipment dedicated to cellular studies
(flow cytometry analyser and microplates readers) that enable us to perform high-throughput screening.
